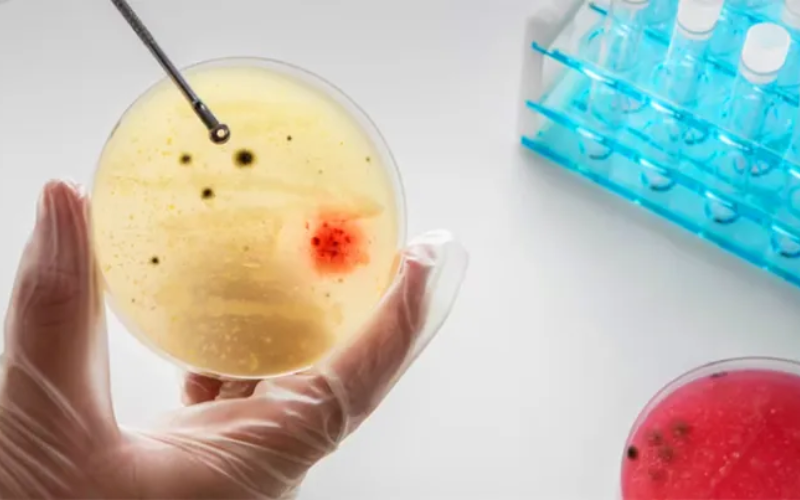

Promovido pelo Instituto de Ciências Matemáticas e de Computação de São Carlos da USP, curso quer capacitar e atualizar alunos e profissionais de áreas como ciências de computação e química orgânica a respeito de conceitos do campo da inteligência artificial; inscrições vão até o dia 30 de abril
Automatização de tarefas em microbiologia é um dos focos do curso gratuito do ICMC USP – Foto: Freepik
Estudantes de graduação e de pós-graduação, além de profissionais interessados em aprender mais sobre o uso de ferramentas de inteligência artificial para automatização de tarefas em microbiologia podem realizar um curso gratuito na USP. Oferecido pelo Instituto de Ciências Matemáticas e de Computação (ICMC), em São Carlos, a iniciativa será ministrada presencialmente pelos pós-doutorandos Antonio Rafael Sabino Parmezan e Danielle Raquel Gonçalves, de 6 de maio a 10 de junho.
Para se candidatar a uma das vagas oferecidas no curso Introdução ao Uso de Ferramentas de Inteligência Artificial para Automatização de Tarefas em Microbiologia, basta preencher o formulário disponível no Sistema Apolo até o dia 30 de abril, acessando este link: https://icmc.usp.br/e/64279. Não é preciso já ter login e senha no sistema para se inscrever, basta inserir as informações solicitadas. É muito importante preencher o e-mail corretamente, pois é pelo contato cadastrado que os inscritos receberão informações sobre o curso, que ocorrerá aos sábados, das 10 às 12 horas.
A iniciativa é coordenada pela professora Solange Rezende, do Laboratório de Inteligência Computacional (Labic) do ICMC, e visa a capacitar e atualizar alunos e profissionais de áreas como ciências de computação e química orgânica a respeito de conceitos do campo da inteligência artificial. Precisamente, serão abordados tópicos de aprendizado de máquina, na modalidade aprendizado profundo, aplicados à química orgânica, sobretudo microbiologia destinada à descoberta de produtos naturais. Além disso, serão oferecidos saberes e experiências sobre o uso de ferramentas de inteligência artificial para tarefas como classificação e contagem de microrganismos.
A metodologia a ser usada durante o curso prevê que existam diversas interações entre os ministrantes e os participantes para realização de atividades práticas com tecnologias de ponta. Segundo os pós-doutorandos do ICMC, há uma alta demanda no setor produtivo, que busca alternativas para automatizar atividades manuais e repetitivas executadas por pesquisadores e clínicos em laboratórios de microbiologia.
Confira a programação completa do curso neste link. Inscreva-se clicando aqui e, em caso de dúvida, escreva para o e-mail parmezan@usp.br
.































